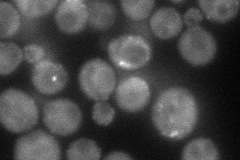
YOR329C
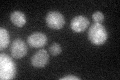
YOR329C
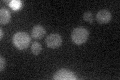
YOR329C

View description
Protein required for normal actin organization and endocytosis; targeting subunit for protein phosphatase type 1; undergoes Crm1p-dependent nuclear-cytoplasmic shuttling; multicopy suppressor of clathrin deficiency
Localization:
Intensity:
Fold change:
Significance:
-
C’ GFP library in SD

cytosol23.33 -
N' NOP1pr-GFP in SD
cytosol,punctate,bud62.8702 -
N' TEF2pr-mCherry in SD

punctate,bud59.3518 -
N' NATIVEpr-GFP in SD

below threshold22.2777 -
N' TEF2pr-VC and Cyto-VN in SD

#N/A0 -
C’ GFP library in SD+DTT
cytosol21.530.92No -
C’ GFP library in SD+H2O2

cytosol22.190.95No -
C’ GFP library in Starvation Media
cytosol24.281.04No -
C’ GFP library on the background of Pup2-DaMP

cytosol -
C’ GFP library on the background of CCT mutant

cytosol17.24150.738782No
